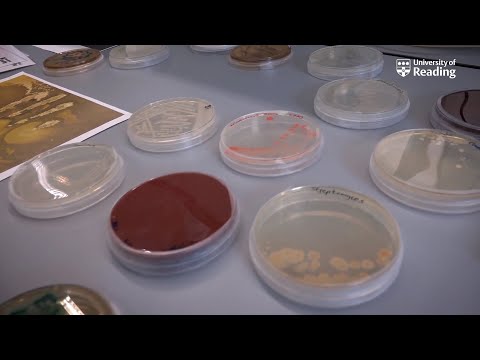
play video

Join our friendly, supportive community who are as passionate about the biomedical sciences as you are.
Our academics will help you make the most of your time with us, and you'll have many opportunities to socialise, collaborate with your peers and gain practical experience.




